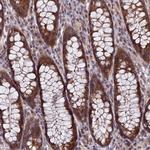
NSMCE1 Antibody in Immunohistochemistry (Paraffin) (IHC (P))

Search
Invitrogen
NSMCE1 Polyclonal Antibody
{{$productOrderCtrl.translations['antibody.pdp.commerceCard.promotion.promotions']}}
{{$productOrderCtrl.translations['antibody.pdp.commerceCard.promotion.viewpromo']}}
{{$productOrderCtrl.translations['antibody.pdp.commerceCard.promotion.promocode']}}: {{promo.promoCode}} {{promo.promoTitle}} {{promo.promoDescription}}. {{$productOrderCtrl.translations['antibody.pdp.commerceCard.promotion.learnmore']}}
产品信息
PA5-59625
宿主/亚型
分类
类型
抗原
偶联物
形式
浓度
规格
保存条件
运输条件
RRID
产品详细信息
Immunogen sequence: RRMGVMTDVH RRFLQLLMTH GVLEEWDVKR LQTHCYKVHD RNATVDKLED FINNINSVLE SLYIEIKRGV TEDDGRPIYA LVN
Highest antigen sequence identity to the following orthologs: Mouse - 92%, Rat - 92%.
靶标信息
The NSMCE1 (Non-SMC Element 1 Homolog) gene encodes a protein that is a key component of the SMC5-SMC6 complex, which is essential for DNA repair and the maintenance of genomic stability. Located on chromosome 16, the NSMCE1 protein interacts with other components of the SMC5-SMC6 complex, including SMC5, SMC6, and NSMCE2, facilitating the repair of DNA double-strand breaks and promoting chromosome segregation during cell division. NSMCE1 is particularly involved in homologous recombination, a critical pathway for error-free DNA repair. Mutations or deficiencies in NSMCE1 can lead to genomic instability, increased sensitivity to DNA-damaging agents, and have been associated with several genetic disorders and cancer predispositions.
仅用于科研。不用于诊断过程。未经明确授权不得转售。